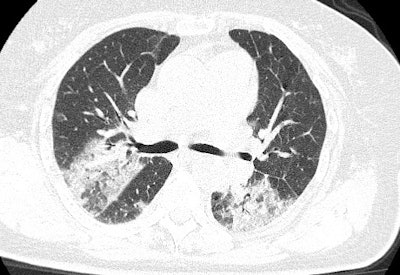

The critical role of CT in diagnosing the novel coronavirus disease (COVID-19) has placed radiology at the frontline of disease management. Researchers discuss preemptive measures radiology departments can take to limit virus transmission in a February 19 article published in the Journal of the American College of Radiology.
Radiologists have played an integral role in understanding and managing the recent coronavirus outbreak, from identifying the most common imaging manifestations of COVID-19 to demonstrating the vital role of CT in diagnosing the disease, especially in cases where initial testing using the standard method -- nucleic acid testing with reverse transcription polymerase chain reaction (RT-PCR) -- results in false negatives.
Recent reports have indicated that the number of confirmed cases has now surpassed 75,000, resulting in more than 2,000 deaths worldwide. As the outbreak continues to expand, more and more radiologists and other medical imaging professionals are likely to be involved in managing individuals who may have COVID-19.
In a preliminary effort to address this concern, a group led by Dr. Ali Gholamrezanezhad from the University of Southern California detailed key safety measures for radiology department personnel.
"U.S. healthcare imaging facilities need to be prepared for the escalating incidence of new cases of coronavirus," Gholamrezanezhad and colleagues wrote. "If appropriately prepared, the radiology department staff can take greater measures to manage the coronavirus outbreak impact on the facility and the personnel."
Due to the highly contagious nature of COVID-19 (mostly through respiratory droplets), the group's foremost recommendation is that radiology departments enforce protocols to limit spread of the disease by staff and equipment, including the following:
- Using portable x-ray equipment at the patient's bedside in order to minimize patient transportation
- Having suspected individuals wear a fit-tested N95 or surgical mask during transport in and out of the radiology department
- Wearing appropriate personal protective equipment, such as disposable isolation gowns, gloves, goggles, and face masks
- Disinfecting CT scanner gantries, ultrasound probes, blood pressure cuffs, the image viewing station mouse and keyboards, and other tools after every contact with individuals suspected of having COVID-19. Radiology departments should contact vendors to identify the best disinfectant to use for each piece of equipment, the authors noted.
"A multidisciplinary committee should convene to outline the guidelines for imaging facility personnel to prevent the virus [from spreading through] human-to-human contact and the department equipment," they concluded. "Implementation of a robust radiology plan can provide protection against further transmission of the virus to patients and staff."